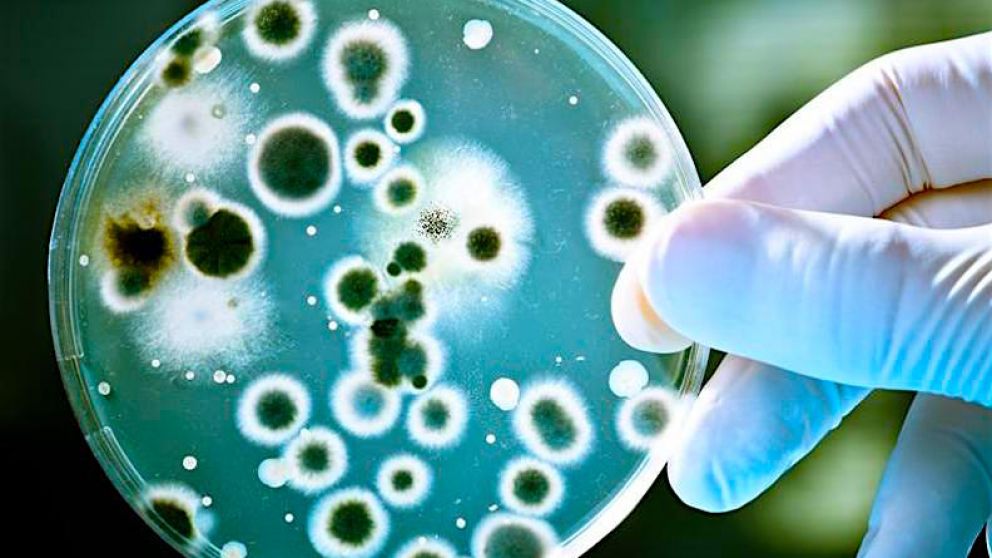
Nueva cepa de coronavirus, más contagiosa y rápida que la original

Nueva cepa de coronavirus, más contagiosa y rápida que la original
Además de propagarse con velocidad, puede hacer que las personas sean vulnerables a una segunda infección después de un primer ataque de la enfermedad
Una nueva cepa del coronavirus (Covid-19) fue identificada: se trata de una cepa más contagiosa que las versiones que se propagaron durante las primeras semanas de la aparición del virus, reveló un estudio de científicos del Laboratorio Nacional de Los Alamos, publicado por el portal Los Angeles Time.
El descubrimiento ocurrió en febrero en Europa, y se propagó rapidamente a Estados Unidos convirtiendose en la cepa más dominante en todo el mundo llegando a marzo. Además de extenderse con velocidad, puede hacer que las personas sean vulnerables a una segunda infección después de un primer ataque con la enfermedad, advirtió el informe.
El docuemento de 33 páginas fue publicado el jueves en BioRxiv, un sitio web que los investigadores usan para compartir su trabajo antes de que sea revisado por pares, un esfuerzo para acelerar las colaboraciones con científicos que trabajan en las vacunas o tratamientos Covid-19. Esa investigación se basó en gran medida en la secuencia genética de cepas anteriores y podría no ser efectiva contra la nueva.
Los científicos de las principales organizaciones que trabajan en una vacuna o medicamentos para combatir el coronavirus revelaron al portal Los Angeles Times que están confiando en la evidencia inicial de que el virus es estable y no es probable que mute de la manera en que lo hace el virus de la influenza, lo que requiere una nueva vacuna cada año. El informe de Los Alamos podría anular esa suposición.
La mutación identificada en el nuevo informe afecta los picos ahora infames en el exterior del coronavirus, que le permiten ingresar a las células respiratorias humanas. Los autores del informe dijeron que sentían una "necesidad urgente de una alerta temprana" para que las vacunas y medicamentos en desarrollo en todo el mundo sean eficaces contra la cepa mutada.
En muchos lugares donde apareció la nueva cepa, rápidamente infectó a muchas más personas que las anteriores que salieron de Wuhan, China, y en cuestión de semanas fue la única cepa que prevaleció en algunas naciones, según el informe. El dominio de la nueva cepa sobre sus predecesores sugiere que es más infecciosa, según el informe, aunque todavía no se sabe exactamente por qué.